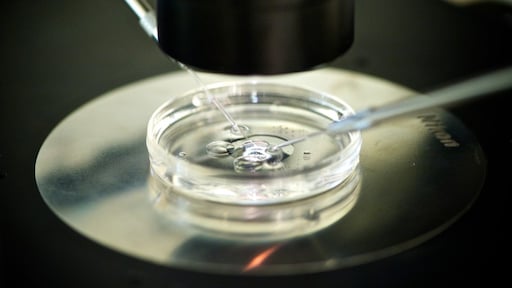
Voor het eerst embryo uit huidcel gecreëerd: 'Kind van twee vaders ooit mogelijk'

Voor het eerst embryo uit huidcel gecreëerd: 'Kind van twee vaders ooit mogelijk'
Wetenschappers in Amerika hebben voor het eerst buiten het menselijk lichaam embryo's gecreëerd die niet voortkomen uit gewone vrouwelijke eicellen, maar uit huidcellen. Mogelijk kunnen vrouwen die nu onvruchtbaar zijn over tien tot vijftien jaar zo toch een kind met hun eigen DNA krijgen. In theorie kunnen ook baby's worden geboren uit het DNA van twee biologische mannen.
In de toekomst is een vrouwelijke eicel niet meer het enige startpunt van leven: elke menselijke cel zou dat kunnen zijn. Vrouwen die nu geen eicellen hebben of eicellen van slechte kwaliteit, zouden daardoor toch een kind kunnen krijgen dat hun eigen DNA heeft.
Sebastiaan Mastenbroek, embryoloog van Amsterdam UMC, legt het proces uit: "Bij een natuurlijke bevruchting komen de vrouwelijke eicel en de mannelijke zaadcel bij elkaar, waardoor een menselijk embryo ontstaat. Beide bevatten 23 chromosomen. De 46 chromosomen bij elkaar zijn de bouwstenen voor ieder mens."
Huidcel
Maar in dit onderzoek zijn de eicellen gemanipuleerd, gaat Mastenbroek verder. Het genetisch materiaal is er namelijk eerst uitgehaald, en vervangen door het genetisch materiaal van een huidcel. Deze huidcel bevat 46 chromosomen. Daarvan wordt de helft uitgeschakeld - dit proces hebben de wetenschappers 'mitomeiosis' genoemd - zodat er weer 23 zijn. Vervolgens wordt deze 'nieuwe' eicel bevrucht met een zaadcel.
De onderzoekers van de Oregon Health and Science University creëerden zo 82 embryo's, schrijven ze in het wetenschappelijke tijdschrift Nature Communications.
Mastenbroek noemt de ontwikkeling 'wetenschappelijk razend interessant' en 'een grote stap vooruit in vruchtbaarheidsonderzoek'. Maar hij benadrukt tegelijk dat het nog zeker tien tot vijftien jaar voordat de methode toegepast kan worden om mensen in de praktijk te helpen. "We moeten nadrukkelijk de verwachtingen op de korte termijn temperen. Er is op dit moment nog veel onbekend. Pas wanneer zeker is dat het werkt, én dat het veilig is, kunnen we de behandeling overwegen."
Een van de vraagstukken die opgelost moet worden, is bijvoorbeeld hoe je precies de juiste helft van de 46 chromosomen uitschakelt, en de goede helft actief laat zijn.
Maar voor de langere termijn kan dit voor mensen met vruchtbaarheidsproblemen zeker een uitkomst zijn, vertelt de embryoloog. In de eerste plaats natuurlijk vrouwen die geen of slechte eicellen hebben. Met hun huidcellen kunnen zij dan een kind krijgen met hun eigen DNA.
Kind van twee mannen of vrouwen
"In theorie is het ook mogelijk dat twee mannen een kind krijgen met het DNA van beiden", zegt Mastenbroek. "Door een eicel te creëren met de huidcel van de één, en die laten bevruchten door de zaadcel van de ander."
Een kind van twee moeders is met deze specifieke methode niet mogelijk, omdat hierbij een zaadcel nodig is. Maar ook dat zal in de toekomst mogelijk worden, legt Mastenbroek uit. In China is een wetenschapper er met een andere methode in geslaagd nageslacht te produceren uit twee vrouwelijke muizen. Het ligt voor de hand dat men deze methode ook voor mensen verder zal willen ontwikkelen.
Met de vooruitgang komt automatisch ook de discussie over de ethische gevolgen op gang, zegt de embryoloog. "Daarom is het wel goed dat de ontwikkeling nog lang duurt, dat geeft tijd om dit gesprek te voeren."
'Hoe gaan we er straks mee om?'
Volgens hem is afwijzing op basis van ethische bezwaren geen oplossing: "De ontwikkeling komt hoe dan ook op ons af. Die is niet te stoppen. Het enige gesprek dat je moet hebben is: hoe gaan we er straks mee om?"
Mastenbroek heeft oog voor de positieve kanten van de mogelijkheden én voor de risico's. "Voor veel stellen kan deze techniek heel goed een oplossing zijn om de kinderwens in vervulling te laten gaan. Dat is natuurlijk heel mooi. Al moet je hier ook het ethische gesprek voeren. Hoe gaan we er bijvoorbeeld mee om als een vrouw van 60 moeder wil worden? Ik denk dat we het er allemaal over eens zijn dat we klonen, dat overigens wereldwijd verboden is, niet willen."
Embryowet Nederland op de schop?
In Nederland is soortgelijk onderzoek op dit moment niet mogelijk, omdat het volgens de embryowet verboden is om embryo's te creëren voor wetenschappelijk onderzoek. Het is alleen toegestaan om overgebleven embryo's te gebruiken.
"Dat is jammer", zegt Mastenbroek. "Het zou meer onderzoek mogelijk maken. Én het zou ons helpen om de reguliere ivf-behandeling te verbeteren. Eén op de 30 kinderen in Nederland wordt uit ivf geboren. Maar nu lukt de ivf-behandeling in 1 op de 4 behandelingen. Met meer onderzoek zouden we dat kunnen verbeteren."
D66 en VVD hebben een wetsvoorstel ingediend om dit verbod uit de wet te schrappen.








